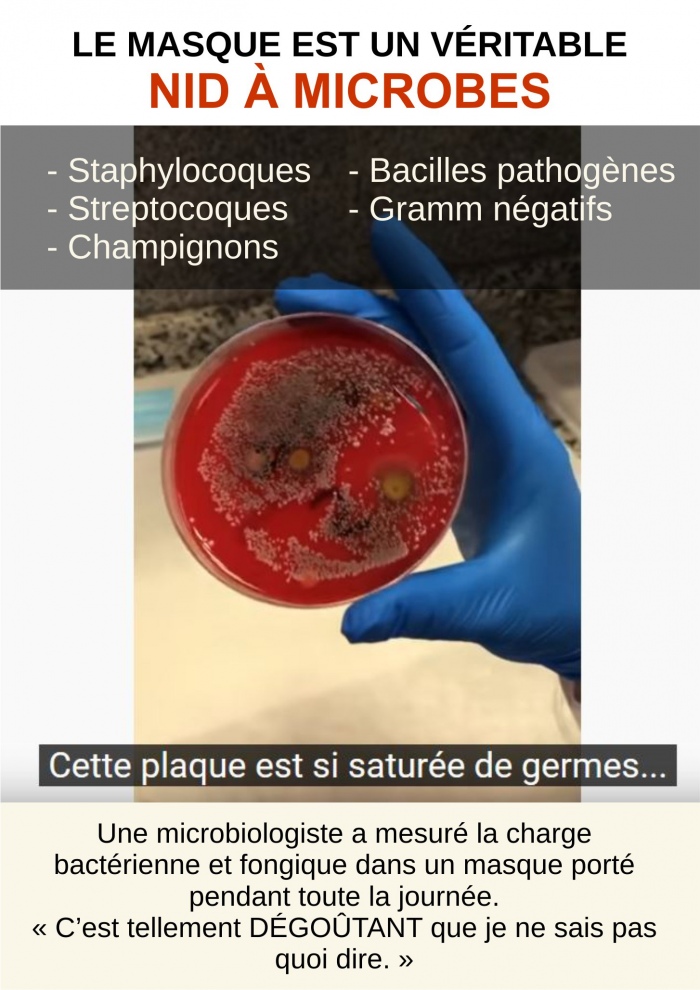

Les masques pour les enfants contaminés par des pathogènes et des parasites.
Les masques pour les enfants contaminés par des pathogènes et des parasites.
Gainesville, FL (16 juin 2021) –
Un groupe de parents de Gainesville, ont soumis six masques faciaux à un laboratoire pour analyse. Le rapport qui en a résulté a révélé que cinq masques étaient contaminés par des bactéries, des parasites et des champignons, dont trois par des bactéries pathogènes dangereuses et provoquant une pneumonie. Aucun virus n'a été détecté sur les masques, bien que le test soit capable de détecter des virus.
Une analyse troublante et inquiétante
L'analyse a détecté les 11 agents pathogènes alarmants suivants sur les masques :
• Streptococcus pneumoniae (pneumonie)
• Mycobacterium tuberculosis (tuberculose)
• Neisseria meningitidis (méningite, septicémie)
• Acanthamoeba polyphaga (kératite et encéphalite amibienne granulomateuse)
• Acinetobacter baumanni (pneumonie, infections du sang, méningite, infections urinaires—résistantes aux antibiotiques)
• Escherichia coli (intoxication alimentaire)
• Borrelia burgdorferi (provoque la maladie de Lyme)
• Corynebacterium diphtheriae (diphtérie)
• Legionella pneumophila (maladie des légionnaires)
• Staphylococcus pyogenes sérotype M3 (infections graves — taux de morbidité élevés)
• Staphylococcus aureus (méningite, septicémie)
Contaminés par différentes souches, les masques deviennent de vrais incubateurs à pathogènes
La moitié des masques étaient contaminés par une ou plusieurs souches de bactéries causant la pneumonie. Un tiers étaient contaminés par une ou plusieurs souches de bactéries responsables de la méningite. Un tiers ont été contaminés par des agents pathogènes bactériens dangereux et résistants aux antibiotiques. En outre, des agents pathogènes moins dangereux ont été identifiés, notamment des agents pathogènes pouvant provoquer de la fièvre, des ulcères, de l'acné, des infections à levures, une angine streptococcique, une maladie parodontale, la fièvre pourprée des montagnes Rocheuses, etc.
Apparemment, le masque favoriserait la fragilisation de la santé en diminuant les facultés immunitaires, augmentant ainsi les risques de se retrouver avec une pneumonie, ou une autre infection des voies respiratoires.
Apparemment, le masque favoriserait la fragilisation de la santé en diminuant les facultés immunitaires, augmentant ainsi les risques de se retrouver avec une pneumonie, ou une autre infection des voies respiratoires.
Les masques faciaux étudiés étaient neufs ou fraîchement lavés avant d'être portés et avaient été portés pendant 5 à 8 heures, la plupart pendant la scolarité en personne par des enfants âgés de 6 à 11 ans. L'un était porté par un adulte. Un t-shirt porté par l'un des enfants à l'école et des masques non portés ont été testés comme témoins. Aucun agent pathogène n'a été trouvé sur les témoins. Les protéines trouvées sur le t-shirt, par exemple, ne sont pas pathogènes pour l'homme et se trouvent généralement dans les cheveux, la peau et le sol.
Conclusion
Rien de ce qu'on nous dit dans les médias et les agneces de santé n'est véridique !
À nous tous de faire nos propres recherches et surtout de ne pas accepter les mensognes comme des vérités !
*****************
"Aucune étude ne montre les avantages d’une politique générale de port de masques en public. Pas l’ombre d’un bénéfice pour se protéger des infections virales respiratoires de type grippal, pas même une légère diminution du risque."
- Pr Denis Rancourt
"Pourquoi disent-ils aux gens qu'ils devraient porter des masques? C'est complètement absurde. Le monde doit se réveiller et comprendre que ce qui se passe en ce moment est une illusion et que cela va aboutir à l'imposition d'autres choses."
- Dr Rashid Buttar
*********
Références:
https://townhall.com/tipsheet/scottmorefield/2021/06/15/a-group-of-parents-sent-their-kids-face-masks-to-a-lab-for-analysis-heres-what-they-found-n2591047?1522